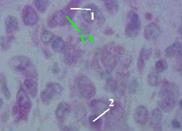

Компоненты и классификация соединительных тканей
| Компоненты соединительных тканей: а) клетки, б) волокна, в) основное аморфное вещество. Классификация соединительных тканей исходит - из природы указанных компонентов - и из соотношения между ними. |
I. Собственно соединительные, или волокнистые соединительные, ткани
| а) Рыхлая волокнистая неоформленная соед. ткань | Рыхлая – значит, в межклеточном пространстве аморфное вещество преобладает по занимаемому объёму над волокнами. Поэтому волокна лежат рыхло. Неоформленная – значит, волокна не ориентированы в каком-либо одном направлении. |
| б) Плотная волокнистая неоформленная соед. ткань | Плотная – основную часть межклеточного пространства занимают волокна (в основном, коллагеновые). Но пучки волокон опять не имеют определённой ориентации. Отсюда – термин «неоформленная». |
| в-г) Плотная волокнистая оформленная соед. ткань – коллагенового (в) или эластического (г) типа | 1) В обеих тканях преобладают волокна, составляющие мощные пучки (ткани – плотные). Причём, они идут в одном направлении (ткани – оформленные). 2) Ткань коллагенового типа содержит только коллагеновые волокна. В ткани эластического типа – и эластические, и коллагеновые волокна. |
II. Соединительные ткани со специальными свойствами
| а) Ретикулярная ткань | Состоит из отростчатых ретикулярных клеток и ретикулярныхволокон, объединённых в сетевидную структуру. |
| б-в) Жировые ткани: белая (б) и бурая (в) | Состоят только из жировых клеток (адипоцитов): - в белой ткани в клетках – одна большая капля жира, - в бурой ткани в клетках – много мелких капель жира и много митохондрий (придающих ткани бурую окраску). |
| г) Слизистая ткань | В межклеточном в-ве – высокое содержание гиалуроновойкислоты, что придаёт ткани гелеобразную консистенцию. |
III. Скелетные соединительные ткани
| а-в) Хрящевые ткани | а) Волокнистая, б) гиалиновая и в) эластическая хрящ. тк. |
| г-д) Костные ткани | г) Грубоволокнистая и д) пластинчатая костные ткани |
| е-ж) Твёрдые ткани зубов | е) Дентин и ж) цемент. (Третья твёрдая ткань зубов – эмаль – имеет эпителиальное происхождение) |
2. Рыхлая волокнистая (неоформленная) соед. ткань: состав
В названии данной ткани термин «неоформленная» обычно опускают, поскольку рыхлой оформленной ткани не бывает
Часто для обозначения ткани используют аббревиатуру РВСТ.
| Локали-зация РВСТ | РВСТ 1) во многих органах окружает все сосуды и тем самым образует строму, или интерстиций,этих органов, 2) кроме того, формирует подэпителиальный (сосочковый) слой кожи. |
| Клеточный состав | В РВСТ могут находиться следующие клетки: 1) тканеобразующие – фибробласты (1) и фиброциты (1А); |
| 2) клетки крови и их производные – все виды лейкоцитов, а также - плазматические клетки (плазмоциты), - макрофаги (2) и - тканевые базофилы (они же – тучные клетки, или лаброциты); 3) клетки, окружающие сосуды: - адвентициальные клетки и - перициты (в стенке капилляров и венул); 4) клетки со специальными функциями: - адипоциты (жировые клетки) и - меланоциты, или пигментоциты. |
 Рис. 9.1. РВСТ
Плёночный препарат
Окраска железным
Гематоксилином
Рис. 9.1. РВСТ
Плёночный препарат
Окраска железным
Гематоксилином
|
| Межклеточное вещество | В межклеточном веществе преобладает по массе и объёму аморфный компонент (5), а также имеются волокна – коллагеновые (3) и эластические (4). |
3. РВСТ – основные тканеобразующие элементы
а) Клетки
| Фибро-бласты: функция | 1) Малоспециализированные фибробласты – интенсивно делятся Зрелые же фибробласты не делятся. 2) Зато зрелые клетки активно продуцируют компоненты межклеточной среды: - белки (коллаген, эластин, фибриллин), формирующие волокна; - протеогликаны и гликопротеины основного аморфного вещества. |
| Фибро- бласты: морфо-логия | 1) Поэтому - значительная часть хроматина находится в состоянии эухроматина, отчего ядро – светлое; - в цитоплазме же хорошо развита шероховатая ЭПС. 2) По форме фибробласты – веретенообразные клетки с отростками. |
| Фибро-циты | Заканчивая функционирование, фибробласты превращаются в малоактивные и тоже неделящиеся фиброциты: узкие, длинные, с плотным палочковидным ядром. |
б) Коллагеновые волокна
| Уровни органи-зации | Эти волокна образованы фибриллярным белком коллагеном. 1) Зрелый коллаген называется тропоколлагеном; в его молекуле – три длинные пептидные цепи, закрученные в единую спираль. 2–4) Путём самосборки последовательно формируются следующие структуры: 2) протофибриллы, 3) фибриллы (обладающие поперечной исчерченностью) и 4) собственно коллагеновые волокна (на их уровне исчерченности уже нет). |
| Виды коллагена | Аминокислотный состав (а значит, и тип) коллагена зависит от локализации последнего. В частности, - коллаген I содержится в РВСТ, - коллаген II типа – в гиалиновой и эластической хрящевых тканях, - коллаген III – в ретикулярных волокнах, - коллаген IV и V – в базальных мембранах. |
| Про-коллаген | 1) Коллаген, как экспортный белок, образуется на рибосомах шероховатой ЭПС. Точнее, на рибосомах синтезируется его предшественник – проколлаген. 2) Отличие от тропоколлагена состоит в том, что на обоих концах трёхцепочечного стержня имеются дополнительные глобулярные последовательности аминокислот, которые препятствуют внутриклеточной самосборке крупных структур – протофибрилл, фибрилл и волокон. |
| Созревание коллагена | Созревание проколлагена происходит и в самой клетке, и вне её. 1) Внутриклеточные события: - окисление (путём т.н. гидроксилирования) строго определённых участков молекулы, - объединение трёх цепей в тройную спираль, - присоединение олигосахаридных цепочек. 2) Внеклеточное созревание: - удаление глобулярных последовательностей, - дополнительное окисление определённых групп, - наконец, объединение молекул в более сложные структуры, где межмолекулярные связи образуются с с помощью окисленных прежде групп. |
в) Эластические волокна
| Эластические волокна обычно гораздо тоньше, чем коллагеновые, но сильней ветвятся. Они состоят из двух белков. 1. а) Фибриллярный гликопротеин фибриллин образует каркас волокна. б) А глобулярный белок эластин встраивается внутри этого каркаса Именно глобулярная форма эластина придаёт волокну эластичность. 2. Промежуточные и конечная формы данных волокон имеют такие названия и состав (первой указана массовая доля эластина, второй – доля фибриллина): окситалановые (0,100%)→ элауниновые (50%,50%)→ зрелые эластические (90%,10%) |
4. РВСТ – прочие клетки (помимо тканеобразующих)
а) Клетки крови и их производные
| Рис. 9.2. Макрофаг в РВСТ Плёночный препарат. Окраска железным гематоксилином | 1) Макрофаги образуются в РВСТ из моноцитов. 2) На данном препарате у них – неправильная форма, чёткие границы, плотное ядро. | 
|
| Рис. 9.3. Плазмоциты в РВСТ Окраска на РНК – метиловым зелёным и пиронином | 1) Плазмоциты образуются из В-лимфоцитов, стимулированных антигеном, и продуцируют антитела. 2) Поэтому у них - много мембраносвязанных рибосом (отсюда – выявление окраской на РНК) и - развит аппарат Гольджи (светлая зона возле ядра – т.н. «дворик»). |
|
| Рис. 9.4. Лаброциты (тучные клетки, тканевые базофилы) в РВСТ Окраска азуром II и эозином | 1) Лаброциты по многом аналогичны базофилам крови: в частности, тоже содержат крупные базофильные гранулы с гистамином и гепарином. 2) На поверхности сорбированы IgE. Связывание с ними попавших в организм антигенов вызывает дегрануляцию и развитие воспалительной или аллергической реакции. |

|
б) Клетки РВСТ со специальными свойствами
| Рис. 9.5. Адипоциты (жировые клетки) в РВСТ Окраска азуром II и эозином | 1) В РВСТ адипоциты, как и лаброциты, обычно лежат возле сосуда – и не поодиночке, а группами. 2) Клетки – такие же, как в белой жировой ткани: весь объём клетки занят большой жировой каплей, которая при приготовлении препарата растворяется. Поэтому видны лишь границы адипоцитов. | 
|
| Меланоциты (пигментоциты) в РВСТ | 1) Основная локализация меланоцитов – базальный слой эпидермиса. Но в особо пигментированных участках кожи (соски молочных желёз, мошонка, анальная область) меланоциты находятся и в сосочковом (верхнем) слое дермы. 2) Меланоциты, в отличие от всех прочих клеток РВСТ, происходят не из мезенхимы, а из нервного гребня. 3) Пигмент меланин находится в мембранных гранулах – меланосомах. Видимо, последние могут передаваться другим клеткам. |
Дата добавления: 2015-08-04; просмотров: 2095;
